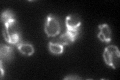
YBR291C
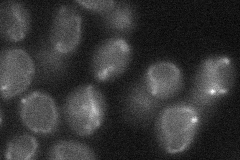
YBR291C

View description
Mitochondrial inner membrane citrate transporter, member of the mitochondrial carrier family
Localization:
Intensity:
Fold change:
Significance:
-
C’ GFP library in SD
mitochondria50.8 -
N' NOP1pr-GFP in SD

mitochondria81.8618 -
N' TEF2pr-mCherry in SD

mitochondria71.2509 -
N' NATIVEpr-GFP in SD

mitochondria72.4571 -
N' TEF2pr-VC and Cyto-VN in SD
mitochondria27.2343 -
C’ GFP library in SD+DTT

mitochondria32.730.64No -
C’ GFP library in SD+H2O2

mitochondria46.150.9No -
C’ GFP library in Starvation Media

mitochondria24.210.47Yes -
C’ GFP library on the background of Pup2-DaMP

mitochondria -
C’ GFP library on the background of CCT mutant

mitochondria52.45351.03238No
